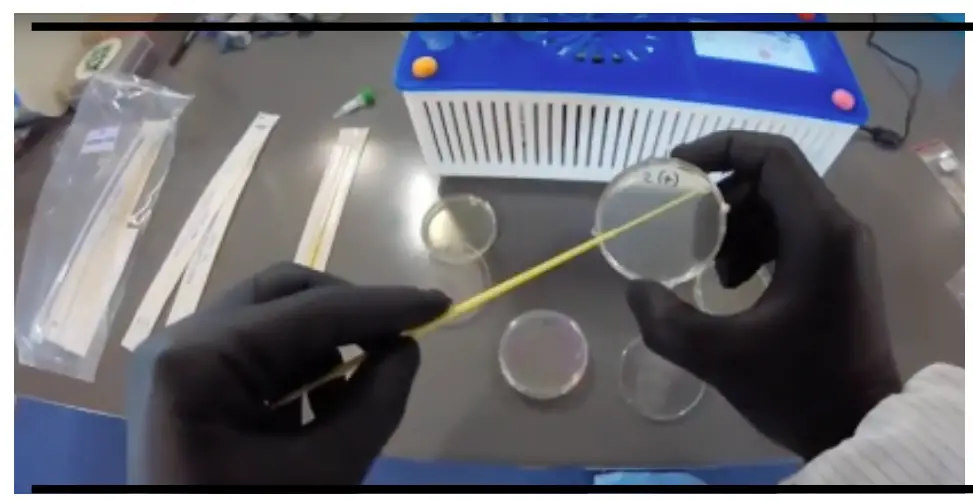
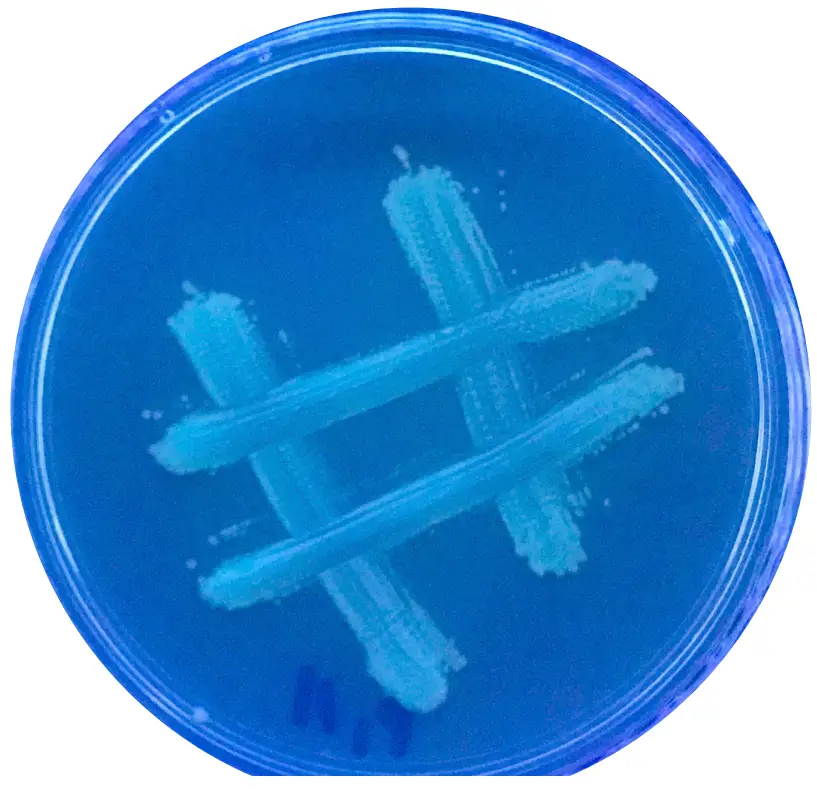

amino CA470318-844 Light-It Kit

Welcome! Let’s get started
This User Guide was created to help you get the most out of your Amino Labs Experience. Even if you are familiar with genetic engineering, science or other Amino Labs™ products, please take the necessary time to read through this guide. This will ensure you practice safe science, store, use and get the most out of your kit and importantly, know what to do in case of a spill or accident.
In the first section, you will learn about your kit’s components, how to store them before and during your experiment, as well as a few tips on activities to complete before you get going. The second section is procedural — these are the step by step instructions on how to run your experiment. Make sure to follow our tips to ensure your best success! The third section covers “what’s next”; how to keep your creations, store or dispose of any leftover ingredients and general clean up instructions. The final section is there to help you — a glossary, troubleshooting, and our contact information.
Amino Labs is excited to welcome you to the world of the Genetic Engineering with the Engineer-it Kit™,
Light-it Kit™ and our entire ecosystem of easy-to-use, easy-to-succeed at products! Following this guide will help ensure that you are getting the most out of your current and future experiences and to keep on making new creations with DNA. Have fun!
Practicing safe science
Genetic engineering and life sciences are safe activities when you follow simple guidelines. Read on to ensure you adopt safe practices.
The kit in your hands contains only non-pathogenic ingredients. These are part of the biosafety Risk Group 1 (RG1) (Biosafety Level 1). This is the most benign level and therefore the safest: with these kits, no special containment or training is required in North America. But you must follow these safety guidelines for your safety and the success of your experiment(s)!
We recommend the system and kits for ages 12+, under adult supervision, and 14+ with or without supervision.
We recommend that an adult empties the discard container. The cleaning instructions must be strictly followed for safety and experiment success. Make sure to store the kit per the instructions found in this booklet.
- Do not eat or drink near your experiments. Keep your experiment at least 10 feet from food, drinks, etc. Under no circumstances should you eat any of the kit’s content.
- Immunocompromised persons: While the ingredients in these kits are non-pathogenic, some persons, such as immunocompromised persons, can be affected by large numbers of bacteria and should talk to their doctor before doing any experiment.
- Wash your hands before and after manipulating your experiment, or the hardware.
- Wear gloves, even when cleaning your station or handling the kit contents (petri plates, loops, etc). This will protect you from your experiment, and your experiment from you. Any latex, nitrile, or general purpose gloves you can find at the pharmacy will do. After you put your gloves on, be aware of what you touch. Try not to touch your face or scratch itches with your gloved hands!
- If using the DNA PlaygroundTM or BioExplorerTM place it on a stable work surface. Keep it level at all times.
- Clean up your station, spills and work surface before and after use. Use a 10% solution of chlorinated bleach generously sprayed onto a paper towel and rub onto any contaminated surfaces. (Careful! This can discolor your clothes). A chlorinated spray cleaner also works.
- Find a container to hold the inactivation bag where you will discard used items. An old 1L yogurt container, large plastic cup or the like will do. Used items (in science, these are often called consumables) will be loops, tubes or used petri dish.
- Eye-wear is not provided but can be worn. You can download a biosafety poster for your space from
www.amino.bio/biosafetyinaction
and complete a short safety quiz at www.amino.bio/biosafety-quiz
If you would like more safe science resources, including a fun video, go to http://amino.bio/practicesafescience
How will I learn?
Learning and prototyping with genetic engineering and cells is becoming accessible to newcomers ages 12+ thanks to dedicated scientists and kits such as the one you are about to use!
One of the easiest ways to learn a new science, hobby or topic is by trying it hands-on. Amino Labs kits make it easy to do science by following the instructions in this booklet. Everything you need is included; each ingredient in the kit is pre-measured and labeled for a beginner-friendly experience. Our all-in-one DNA Playground minilab (mini-laboratory) decreases setup time, mess, guesswork and the need to collect and calibrate multiple machines. The included instructions should be easy-to-follow for everyone but may contain some new terms for which we have added a glossary at the end. Don’t hesistate to flip to it during or before your experiment.
An essential addition to our ecosystem are the free Virtual Bioengineer™ simulations developed with the educators at the Biobuilder Educational Foundation. These simulations are 20 minutes guided experiences that make it easy to practice using a DNA Playground™ and experiment kits beforehand. The simulations includes additional information on the manipulations and a more in-depth look into the kit components. We recommend it strongly!
Complete online at www.amino.bio/vbioengineer.
View Real-time tutorials videos at youtube.com/c/AminoLabs.
Would you like for an Amino Labs team member to guide you through your journey? Try the Cyber Workshop & Tutoring, a 3-day+ experience completed via video conferencing.
www.amino.bio/products/cyberworkshop.

Are you interested in the theory behind the experiment? In going deeper on the science, learning pro-tips and eventually moving onto advanced genetic engineering? The Zero to Genetic Engineering Hero book is for you. Find out
more at www.amino.bio/book

Discover your Light-it Kit™
The Light-it Kit™ lets you use your engineered bacteria to create living paintings that change color only if you shine the right color of light on them! By following the experiment instructions on the next pages, you will create selective agar petri dish “canvases”, use the bacteria “paintbrushes” to create your living art on the agar surface and incubate under a specific LED light color over 18 to 24 hours to create beautiful bioart.
If you’ve completed an Amino Labs’ Canvas Kit before you’ll remember that once your bacteria grew, it automatically started changing colors. In the case of this kit, the colored proteins that make the cells change color won’t be created unless you ‘turn them on’ using the LED provided with your kit or in your DNA Playground Large. That is because, in the DNA plasmid that was engineered in the cells, there is a ‘genetic switch’ that is ‘turned off’. That’s right! Just like in computer programming, behaviors in the cells can be turned ‘on’ and ‘off’ using temperature, chemicals, light and other environmental conditions. The DNA plasmid for the Light-kit was created by the Andreas Moeglich lab at the University of Bayreuth in Germany. You can learn more about genes, genetic switches, and how to use chemicals, light, and temperature to activate DNA programs by reading Chapter 7 of the Zero to Genetic Engineering Hero book, www.amino.bio/book. Have a look at the Induce-it KitTM and the Heat-it KitTM on www.amino.bio to do more other genetic switch experiments.
Kit Components
![]() | Agar Powder: This LB agar powder is industry standard. Each tube of LB agar powder can make 45 mL of molten LB agar (3.5% w/v). Agar is both the surface the bacteria grow on and the food they eat to grow.The agar may also includes black pigment to make your agar darker to allow the bacteria color to really pop! ¹ |
![]() | Selection Marker: Amino Labs’ proprietary antibiotic delivery system helps stabilize antibiotics for shipping and long-term storage. These capsules have a measured amount of antibiotics for 45 mL of molten LB agar. In such small quantities, these antibiotics are in very small amounts, much lower than a typical infant dose. Do not ingest them, however!¹ |
![]() | Cell stab: These bacteria are engineered to change color when they react to light. They are non-pathogenic. |
![]() | Sterile Water: Sterility is critical when you’re bioengineering. This distilled water has been sterilized with an autoclave in order to ensure there are no contaminating organisms present. This 50 mL volume is enough to make four LB agar plates.¹ |
![]() | Loops: Inoculating loops are used for transferring 10 u L (yellow loop) or 1uL (blue loop) of liquid and/or other tasks. Yellow loops are great for spreading out bacteria on agar. |
![]() | Petri Dish / Plate: 6cm petri dishes are large enough for typical lab experiments, help save on the cost of reagents and reduce waste. |
![]() | Inactivation Bag: A heavy duty bag to put all of the kit waste in. After your experiment, follow the label instructions and add bleach and water to the bag to inactivate all the samples and practice safe science. |
![]() | Paintbrush: Sterile swabs and picks help you paint bacteria on the agar |
Unpacking & storing your kit Inactivation Bag
For a better shelf life and successful experiments, place your Light-it kit in a refrigerator at around 4°C.
Do Not Freeze your kit!
Necessary Equipment
For Best results:
- Microwave
- DNA Playground Large with the built-it LED to activate the bacteria color-producing gene.
- Black-light: The Light-it bacteria color is fluorescent, meaning that they will be most visible under black-light.

Safety Supplies 
Disposable container 500ml-1L
to hold tubes, loops and other contaminated waste (e.g., yogurt container, plastic cup).
Latex or nitrile gloves
like the ones found at a pharmacy. 1 pairs/person if you will keep & reused each day, or 4 pairs/person if not saved & reused.
Chlorinated bleach spray
1 regular bottle (or you can mix a 10% solution: 1 part bleach to 9 parts water in a spray bottle)
Bleach ~250 mL
to inactivate all the experiment materials at the end of the experiment.
Timeline
The Light-it Kit™ takes 2 days of hands-on activity to complete, and 18 to 24 hours to see results. four “activities” make up the Light-it Kit experiment:
- Make selective plates
Day 1, 20-35 minutes - Create your bacteria paint
Day 1, 10-20 minutes , 18-24 hrs incubation - Stencil your art on paper
Day 2, 5-10 minutes, variable - Prepare your LED
Day 2, 5 minutes - Paint with your bacteria paint
Day 2, 10-20 minutes , 18-24 hrs incubation
Experiment Protocol
Prepare your space
Goal Set yourself up for sucess.
Materials from the kit
(1) Inactivation bag
Materials not in your kit
(1) 1L discard container
Chlorinated bleach spray or wipes
Paper towels
(1/person) Pair of gloves
Make sure you have the necessary materials as explained on in the introduction, including gloves, microwave, and cleaner before you start.
- Put on your gloves, and if you have one, your lab coat or apron.
- Set your inactivation bag inside your disposable 1L yogurt-type container. You will use your inactivation bag to dispose of:
• your tubes of cells if you are not saving them for a future experiment*,
• any used inactivation loops,
• bacteria paint palette once it is used (unless you are saving it to paint your other canvases later)*
• any empty tubes like the agar, and selection tubes,
• any gloves that have touched bacteria.
You can dispose of paper and plastic packaging in the regular garbage can, as well as gloves if you have not accidentally touched bacteria. - Wipe down your work surface with the chlorinated bleach spray or wipes.
- Set down your DNA Playground, BioExplorer, or other personal lab equipment on or near your work surface (it is recommended you use an incubator for this experiment) . Make sure it is level and on a stable surface. Refer to the instruction manual to make sure you know how to use your equipment safely.
* If you are saving the tubes of cells or your painting palette for a future experiment, place them back in their ziploc bag after use and store them in a refrigerator. We recommend you use a sealed plastic container to store all your experiment materials inside a refrigerator if you also use this to store food or drinks. *
Creating LB Agar Plates Day 1, 25 minutes
Goal Create selective LB agar plates.
Materials from your kit
(1) 50 mL sterile water
(1) LB agar powder
(1) antibiotic pill
(4) 6 cm petri dishes
(1) Sharpie marker
- Prepare
Label each petri dish with a sharpie-type pen. Make sure to label the bottom of the petri dishes (the bottom is the half with the smaller diameter of the two. The bottom fits inside the lid and it may have star-shaped ring around it). Label 4x S. (for selective) + Add [your initials] if doing this in groups with multiple kits.
- Mix the Agar
Unscrew the lid from the sterile water bottle and keep it loosely on top of the bottle to prevent any contaminants from entering the water, but allowing air to escape. This will prevent pressure build-ups. - Place the bottle in the microwave and heat the water until you see it boil. You can use 45 seconds as your starting time but you have to see a rolling boil where many bubbles are rising constantly before you continue to the next step. Careful, the bottle will be hot! !! If the water does not boil, the agar powder will not dissolve and your plates will not solidfy !!

- Add the tube of agar powder to the boiling water. Careful, the water is hot! Some agar powder may “clump” around the lip of the tube due to the water evaporation. This is okay, we have accounted for this possible loss.
Note: If you’ve made petri dishes with agar before, you’ll notice this agar is dark gray instead of yellow. We’ve added some pigment in this agar to help contrast with the fluorescent Light-it kit color. - Microwave the water and agar powder in 4 seconds intervals until you see it boil again. Instead of a rolling boil, you will see more of a foam forming above the molten LB agar liquid. Careful, the liquid will boil over if you microwave in more than 4 sec. increments. After you see the liquid foaming, swirl to mix for 10 seconds. Try not to shake vigorously as this will create bubbles in your agar and make the surface of your agar uneven.

Make selective (S.) plates
Note: If you’ve done the Engineer-it Kit before, note that you will not be making a non selective plate. All 4 plates will be selective agar. - Add the antibiotic pill to the bottle of agar and gently swirl for a few minutes until the contents of the pill have dissolved. Do not introduce bubbles into the LB agar: don’t swirl too vigorously. The gelatin capsule may not fully dissolve. The important thing is that the contents of the capsule do dissolve.

- Once the antibiotic pill is dissolved, pour the molten LB agar into the bottom half of the 4 petri dishes. Place the lids 3/4 of the way back on so that the agar can cool and dry (solidify).
Pro-tip: If there are water droplets on the surface of the LB agar, this can disrupt your art. Bacteria that you will be painting with can enter a droplet and spread throughout the droplet therefore ‘smudging’ your art. To avoid this make sure the lid is partially over top to allow for evaporation and a dry LB agar surface. - Let the LB agar harden. This can take up to 20 minutes depending on how warm and humid your environment is. You will use 1 plate in the next step. You can store the remaining 3 plates in the ziploc bag in the refrigerator for day 2.

Troubleshooting tip
If your plates do not solidify after 30 minutes it is very likely that the water was not boiled enough to dissolve the agar powder. As a ‘hack’, you can pour all of the petri dish content back into the water bottle and microwave until you see it boil. Swirl to mix and re-pour your plates.
Checkpoint – Agar Plates
Use this guide to check if you are ready to move onto the next step.
A perfect Agar plate is solid and has a smooth surface.
If your agar has the dark pigment in it, you will of course not be able to see through it, but you should notice a smooth surface and nice gloss on the surface of a well-made agar plate, no matter the color. Congrats!
An agar plate that is cloudy and/or bumpy and/or soft is not ideal and it means you needed more boiling or mixing.
Troubleshooting tip
If your plates do not solidify after 30 minutes it is very likely that the water was not boiled enough to dissolve the agar powder. As a ‘hack’, you can pour all of the petri dish content back into the water bottle and microwave until you see it boil. Swirl to mix and re-pour your plates.
Unfortunately, if the agar does not solify, this means you need to halt your experiment and complete the troubleshooting guide and follow the instructions at www.amino.bio/troubleshoot

Create your Light-it paint palette Day 1, 20 minutes + 18-24 hours wait time
Goal Create living paintings
Materials from your kit
(1) Selective Agar plates
Tube of Light-it Paint
1 Yellow Loop
- Prepare
Turn on your incubator to 37°C and make sure that none of the led light colors in the incubator are on. If possible, to get the best result you should paint with the Light-it bacteria in a darken room since the bacteria reacts to light. If you can turn the lights off, do so. Complete darkness is not necessary.
Streak Note:
If you have printed instructions, you can place one petri dish on top of the double streak stencils on the right. If not, you can refer to the pattern on screen in the steps below. For this bacteria streaking, it is not important to be precise, it is simply necessary to cover most of the petri dish surface with the bacteria. - Open one of the yellow loop by holding the straight end of it, not the loop end. Prepare by removing it half-way from the packaging. Don’t let the loop end touch anything yet! Set down next to your agar petri dish.
- Open the black bag containing your Light-it bacteria tube, and open the tube. Keep the black bag for re-use. Try keeping the tube and your bacteria shaded from light. Dip the loop end of your yellow loop into the stab of Light-it bacteria.
- Using the end of the loop you dipped in the colored bacteria, trace a zigzag line like on the stencil on the right.
- Discard the loop in your inactivation bag or discard container.
- Close your tube of Light-it bacteria. Return it to the black bag and place it in the refrigerator inside a ziplock bag or sealed container.

- Incubate Overnight
Flip your petri dish upside down so that the side with the agar is facing up, and set the humidity chamber on top of your petri dish. You will find the humidity chamber inside the incubator of the DNA Playground if this is your first time using it. - Incubate your streaked plate upside down at ~37°C for 16 to 24 hours without any LED light in the DNA plya ground turned on. This will be your painting palette to create your living art tomorrow.
- Make sure to remember to lock the incubator door!

Checkpoint – Bacteria Paint
Use this guide to check if you are ready to move onto the next step.
A perfect bacteria painting palette plate has lots of bacteria on its surface. These bacteria should not be colored since no LED light was turned on during incubation. It is possible to see a faint color under UV/black light after incubation if there was light that
reached the bacteria prior to the incubation, but it should be minimal.
Proceed to the next page. This suggests that you have made your LB agar petri dishes properly and have the right amount of antibiotics.
A bacteria plate showing just a few dots of white or lightly colored bacteria under UV/ black light after incubation can either require more time to grow so that you can obtain a larger quantity of paint, or can be used right away. If you are using it right away, simply dip your sterile bacteria paintbrush in the bacteria dots (called colonies), and remember to share with others if you are working on a team!
If you see no growth on your plate:
- If your incubator was not at 37°C or is homemade, incubate for another 24hrs.
- If you are certain you incubated at 37°C, or incubated for 48hrs and still have no colonies, you might not have had cells on your loop when you streaked. Repeat Step 2: Grow your bio paint on the plate.
- If you still have no growth after repeating Step 2, contact us at [email protected], and we will help you succeed.

Paint with bacteria! Day 2, 15 – 30 min + 24+ hours wait time
Goal Create living paintings
Materials from your kit
Selective Agar petri dish
Light-it bacteria paint palette
Blank stencils and pen/marker
Yellow/Blue Loops
Bacteria Paintbrushes
DNA Playground Large
- Prepare
Using the screen controls on the DNA Playground under the ‘Incubator’ tab, use the sliders to select the color BLUE of the LED. Today, you will create the Light-it paint palette which you will use to create your art. - Turn your incubator on to 37°C.

- Sketch!
Using the blank stencils in your kit, take a marker or pen and draw your art piece for the petri dish(es) you would like to paint. Remember that a simple image works best for your first time painting! Since your agar has some gray pigment in it, using a dark marker to draw your stencil with will work best.
Paint your art with the Light-it painting palette bacteria.
Note that the DNA Playground can incubate 8 petri dishes at a time under the Blue light, so if you are working in teams, make sure to plan out hown many petri dishes you want to incubate at once. If you have painted petri dishes that don’t fit in the incubator, you can place them in a ziplock bag, in a dark box in the refrigerator until its time to incubate. - To get the best result you should paint with the Light-it bacteria in a darken room. Turn the lights off if you can. Complete darkness is not necessary.
- Set one of the selective petri dish you made yesterday on top of your sketched stencil or the image stencil from the kit. You’ll notice that the dark pigment in the agar makes it a little bit difficult to see the image below.
You can use a marker to make your stencil image darker and easier to see through the gray agar. - Open your painting palette petri dish and using the yellow and blue loops, and the bacteria ‘paintbrushes’, paint your art onto the agar by dipping directly into the bacteria paint. Then, trace your image, gliding on top of the agar on your new petri dish.
Remember that the agar is like a Jell-O, be careful not to puncture it as you paint and dip into your paint.
Note that you will not see the bacteria appear right away, but you may be able to see a “wet” trace where you have painted on top of the agar. You only need to dip into the Light-it bacteria to collect bacteria as they will transfer, no need to scoop them out of the petri dish. - Return any unused petri dish to the ziplock bag and refrigerate. Close the Light-it paint petri dish and return it to a ziplock bag to refrigerate.
Incubate - Make sure that the Blue LED light is turned on in the DNA Playground incubator.
- Flip your petri dish upside down so that the side with the agar is facing up, and set the humidity chamber on top of your petri dish.
- Incubate your painted plates at ~37°C for 18 – 24 hours. See your living art appear and change color to match the LED!
- Make sure to remember to lock the incubator door!

Did your bacteria grow?
Goal Verify if your bacteria art grew
See your living painting appear over the next 18-24 hours! The Light-it blue color is fluorescent, meaning that it will show up brightly under a UV/black light.
If you have unused canvas petri dishes, repeat step 4 for those petri dish.
Note: If you cannot see any growing cells at all after 48 hours or they have not changed colors, your experiment may have failed. See our troubleshooting guide at the end of the manual, compare results with your group, if applicable, or contact us with photos of your result and any documentation of your process so that we can help you succeed in the future. Make sure, if possible, to also review the video tutorials on the youtube channel (youtube.com/aminolabs) to see if you missed any steps!
What can you expect the Light-it bacteria to look like?
- Under UV/black light

Congratulations!
You have now joined the global community of bioartists and genetic engineers! Share your results with friends and our growing community. @aminobiolab
Happy with your artwork? There are many opportunities to share it online, exhibit it in your community and even participates in contests and artist communities on the web!
Don’t forget, you can preserve your bioart with our Keep-it KitTM . For now, let’s make sure you dispose of and store your remaining material correctly.
Storage, Disposal, Clean Up
After you sees your results, all experiment Petri dishes, tubes of cells and loops should be in the inactivation bag in your discard container. Disposing of experiment materials is an integral part of the experiment. Always wear gloves for cleanup!
A. Preserving Petri dishes: If you want to preserve the living paintings or experiment results in Petri dishes instead of disposing of them, use one of our Keep-it kits. This will help you maintain the petri dish by pouring a special resin on top. If you do not have Keep-it Kits on hand but will be getting one soon, keep the Petri dishes you want to preserve in a ziploc bag in a cool area and out of sunlight in the meantime. You can refrigerate it to keep it “fresh” for up to a month.
B. Reusable materials: If you have DNA in your kit, it can last up to 6 months when stored in a refrigerator. If you wish to keep it, store it in a ziploc bag inside a sealed plastic container in a refrigerator away from food items. If you do not wish to keep it, add to an inactivation bag. Make sure the lids are separate from the tubes so that the inactivating liquid can get inside. If you see any mold or unknown bacteria growing on any material at any point, immediately inactivate them by using a solution of bleach water. Follow the inactivation instructions below. If you are out of inactivation bags, use a sturdy ziploc type bag or disposable container with a lid. Always wear gloves when handling experiment materials and cleaners!
C. Unused ingredients: If you did not use all the agar Petri dishes you poured, store these for later use. Store them in their ziploc bag within a sealed container in the refrigerator for up to a few months. Keep them away from food items. If you see any mold or unknown bacteria growing inside, then you should always immediately inactivate the Petri dishes.
D. Inactivation: Make sure all bacteria, agar, tubes, loops, paintbrushes, Petri dishes, contaminated gloves, and other non-paper material you are not keeping are in the inactivation bag. Remember that any paper packaging like loop wrappers, plastic bags, and gloves that have not touched bacteria go in the regular garbage or recycling.
Make sure all the tubes have their lids off once in the inactivation bag and add a solution of 1 part bleach to 4 to 6 parts water to the inactivation bag. Close the bag and let sit for 24 to 48 hours before discarding the liquid in the toilet and the solids & bags in the garbage. Step-by-step instructions are on the inactivation bag and in an Inactivation video on youtube; youtube.com/c/Amino Labs. Spray some chlorinated bleach cleaner in the discard container once emptied if it has become contaminated by experiment materials. Let it sit for an hour before wiping down. You can wait to wipe it down until you empty out your inactivation bags the next day.
E. Clean your workspace: Use a chlorinated spray cleaner, wipes, or a solution of 1 part chlorinated bleach to 9 parts water to wipe down your work area and equipment. You can wipe down the minilabs with this solution and follow it with an eyeglass or window cleaner to remove the inevitable streaking from the bleach cleaner. Never use rubbing alcohol (isopropyl alcohol) on the DNA Playgrounds.
Glossary
Agar: is a Jello-like substance that serves as a growth media for bacteria. It is mixed with our bacteria’s favorite food: Lysogeny broth (LB). LB is made up of yeast, vitamins, and minerals. LB can also be found liquid-form.
Antibiotics: When you transform bacteria, they will become resistant to a type of antibiotics no longer used in hospitals. This antibiotic will be mixed in with the agar and LB so that, as you incubate your culture, only transformed bacteria will grow. This is called a “selection marker”.
Autoclave: An autoclave is a machine used to carry out industrial and scientific processes requiring elevated temperature and pressure in relation to ambient pressure/temperature. In life science, autoclaves are used to sterilize equipment and supplies by subjecting them to pressurized saturated steam at high temperatures (around 250 °F) for several minutes, up to an hour. Autoclaves are similar to some baby bottle sterilizers which you might be familiar with.
Buffers: Buffers are saline solutions that help, in this case, open up the cell membranes so that they may take up new DNA.
Cells: Cells are tiny, living units that function like mini-factories. Bacteria are single-celled organisms (unicellular) microorganisms. They are different from plant and animal cells because they don’t have a distinct, membrane-enclosed nucleus containing genetic material. Instead, their DNA floats in a tangle inside the cell. Individual bacteria can only be seen with a microscope, but they reproduce so rapidly that they often form colonies that we can see. Bacteria reproduce when one cell splits into two cells through a process called binary fission. Fission occurs rapidly, in as little as 20 minutes.
Competent Cells: Since DNA is a very hydrophilic molecule, it won’t normally pass through a bacterial cell’s membrane. In order to make bacteria take in the DNA plasmid, the cells must first be made “competent” to take up DNA. This is done by creating small holes in the bacterial cells by suspending them in a solution with a high concentration of calcium (the transformation buffer). DNA can then be forced into the cells by incubating the cells and the DNA together on ice, placing them briefly at 42°C (heat shock),
and then putting them back on ice. This causes the bacteria to take in the DNA and is called “Transformation”.
DNA: The DNA is the set of instructions that tell the cell how to function like a computer program tells your computer what to do. DNA stands for Deoxyribonucleic acid.
DNA plasmid: A plasmid is a small circular piece of DNA (about 2,000 to 10,000 base pairs) that contains essential genetic information for the growth of bacteria. Bacteria share vital information by passing it among themselves in the form of genes in plasmids. By inserting a new plasmid in our bacteria, we can get them to produce things for us,can get them to produce things for us, ike mini-factories. In this case, we have a plasmid that encodes for the creation of colorful pigments.
Genome: a genome is all genetic material of an organism. It consists of DNA. Learn more about genomes in the What is DNA? simulator on amino.bio
Heat shock: is when the cells are moved from icecold to warm temperature, typically 42°C, to take in DNA plasmids more efficiently.
Inoculation: is when you introduce bacteria into a medium suitable for its growth.
Inoculating Loops: are used to transfer liquids, cells, and DNA from one vial to the next instead of traditional lab pipettes, making your job easier, and less costly. They come in different pre-calibrated sizes, so you do not need to worry about minuscule liquid volumes. They are also used to spread bacteria on an agar surface without puncturing the soft agar.
Non-Selective: A non-selective plate means that any cells/bacteria put on this agar will grow as long as they are oxygen-loving organisms (called aerobic bacteria).
Plates (or Petri dish): A petri dish is a small plastic container used to culture (grow) bacteria in a controlled environment. Recovery period: is the period after the heat shock in which the cells develop their antibiotics resistance and start dividing.
Selective: A selective plate means it contains antibiotics. When you insert a new DNA program into cells to make them create pigments, or anything else, you also put a “selective marker” (antibiotics resistance) inside the code. This means that only the cells that have taken up the new program will be able to grow on a plate that has the antibiotics mixed in. You only get the cells you transformed!
Transformation: See competent cells.
Troubleshooting
Here are some possible common issues: Your agar is too wet/ doesn’t solidify:
When done correctly, the agar will be the consistency of Jell-O. If it is not:
- You likely did not heat (boil) the water before, or after adding the LB agar powder
- You might not have added all the powder from the tube, resulting in too much water vs. LB agar powder.
- You may not have fully dissolved the powder, meaning it cannot turn into a gel and will look cloudy. You can practice by making Jell-O! Next time heat and swirl longer to ensure the powder is fully dissolved.
You don’t have any colonies and its been 24+ hours:
Don’t worry, every scientist has experienced this, and it can take some practice before success.
- Double check that your incubator is on at 37°C. If it is not, or if you are growing at room temperature, then it can take much longer to see the bacteria colonies. Keep waiting! If you kept the second half of your recovered cells, you can pour them on your plate after 48 hours of seeing no engineered colonies grow and keep incubating.
- You may need to try again to hone your skills. See our Youtube videos for tips and tricks on how to improve your chances of success.
Your colonies of bacteria grew, but they are the wrong color or there is mold on your petri dish: Danger! If at the end of, or during, the incubation period your resulting bacteria/plate is: a)not the right color; b)is black when it shouldn’t be, this is a sign that your culture is NOT YOUR ENGINEERED BACTERIA. You should immediately inactivate it and clean your space and unit.
To inactivate it, either add it to the inactivation bag or pour 100% chlorinated bleach into the dish, put the lid on and let it sit for 24 hours before throwing it out: The strong oxidizing environment degrades any living organisms. After 24 hours, if there are still organisms present add more concentrated bleach until it is almost full, and let stand for a further 24 hours.
There may be mold in your environment. We recommend, getting a small air purifier with a HEPA filter for the room.
*Always be aware that concentrated bleach is a strong oxidizing agent and if poured on the skin can cause irritation, and on clothes remove color. Follow the safety and handling protocol on the manufacturer’s label.*
Find an interactive troubleshooter online at
amino.bio/troubleshoot. We recommend using it for tips, tricks and to claim your Success Guarantee Kit if you need of one.
If anything else causes you issues, please contact us : [email protected]
More Information

All Amino Labs products, from the hardware to the DNA, are invented, designed, manufactured and shipped by us, in our laboratory- workshop in Canada and we’d love to hear your feedback and suggestions to continue to make our products better and fitting to your needs. Answers to your questions and help are also just an email away.
Help and General inquiries: [email protected]
Feedback, Suggestions, Comments: [email protected]










































